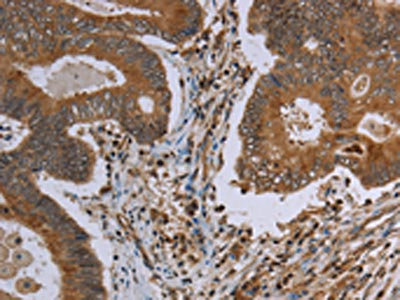

MAVS Antibody
-
中文名稱:MAVS兔多克隆抗體
-
貨號:CSB-PA846893
-
規格:¥1100
-
圖片:
-
The image on the left is immunohistochemistry of paraffin-embedded Human colon cancer tissue using CSB-PA846893(MAVS Antibody) at dilution 1/30, on the right is treated with synthetic peptide. (Original magnification: ×200)
-
Gel: 8%SDS-PAGE, Lysate: 40 μg, Lane: Mouse heart tissue, Primary antibody: CSB-PA846893(MAVS Antibody) at dilution 1/250, Secondary antibody: Goat anti rabbit IgG at 1/8000 dilution, Exposure time: 1 minute
-
-
其他:
產品詳情
-
Uniprot No.:
-
基因名:
-
別名:CARD adapter inducing interferon beta antibody; CARD adaptor inducing IFN beta antibody; Cardif antibody; DKFZp666M015 antibody; FLJ27482 antibody; FLJ41962 antibody; IFN B promoter stimulator 1 antibody; Interferon beta promoter stimulator protein 1 antibody; Ips 1 antibody; IPS-1 antibody; Ips1 antibody; KIAA1271 antibody; MAVS antibody; MAVS_HUMAN antibody; Mitochondrial anti viral signaling protein antibody; Mitochondrial Antiviral Signaling antibody; Mitochondrial antiviral signaling protein antibody; Mitochondrial antiviral-signaling protein antibody; Putative NF kappa B activating protein 031N antibody; Putative NF-kappa-B-activating protein 031N antibody; Virus induced signaling adapter antibody; virus induced signaling adaptor antibody; Virus-induced-signaling adapter antibody; VISA antibody
-
宿主:Rabbit
-
反應種屬:Human,Mouse
-
免疫原:Synthetic peptide of Human MAVS
-
免疫原種屬:Homo sapiens (Human)
-
標記方式:Non-conjugated
-
抗體亞型:IgG
-
純化方式:Antigen affinity purification
-
濃度:It differs from different batches. Please contact us to confirm it.
-
保存緩沖液:-20°C, pH7.4 PBS, 0.05% NaN3, 40% Glycerol
-
產品提供形式:Liquid
-
應用范圍:ELISA,WB,IHC
-
推薦稀釋比:
Application Recommended Dilution ELISA 1:2000-1:5000 WB 1:500-1:2000 IHC 1:50-1:200 -
Protocols:
-
儲存條件:Upon receipt, store at -20°C or -80°C. Avoid repeated freeze.
-
貨期:Basically, we can dispatch the products out in 1-3 working days after receiving your orders. Delivery time maybe differs from different purchasing way or location, please kindly consult your local distributors for specific delivery time.
-
用途:For Research Use Only. Not for use in diagnostic or therapeutic procedures.
相關產品
靶點詳情
-
功能:Required for innate immune defense against viruses. Acts downstream of DHX33, DDX58/RIG-I and IFIH1/MDA5, which detect intracellular dsRNA produced during viral replication, to coordinate pathways leading to the activation of NF-kappa-B, IRF3 and IRF7, and to the subsequent induction of antiviral cytokines such as IFNB and RANTES (CCL5). Peroxisomal and mitochondrial MAVS act sequentially to create an antiviral cellular state. Upon viral infection, peroxisomal MAVS induces the rapid interferon-independent expression of defense factors that provide short-term protection, whereas mitochondrial MAVS activates an interferon-dependent signaling pathway with delayed kinetics, which amplifies and stabilizes the antiviral response. May activate the same pathways following detection of extracellular dsRNA by TLR3. May protect cells from apoptosis.
-
基因功能參考文獻:
- The mitochondrial antiviral signaling adaptor protein (MAVS) oligomers and high MW aggregates coexist upon constitutively active retinoic acid-inducible gene I (RIG-I) ectopic expression and virus infection. Anchoring of MAVS to intracellular membranes is essential for an appropriate polymerization process allowing functional high MW aggregates to occur. PMID: 29385716
- MAVS isoforms are truncated, which prevents its spontaneous aggregation in antiviral innate immune signalling PMID: 28607490
- these results demonstrated that HAUS8 may function as a positive regulator of RLRVISA dependent antiviral signaling by targeting the VISA complex, providing a novel regulatory mechanism of antiviral responses PMID: 29916539
- results suggest that ASC, as a negative regulator of the MAVS-mediated innate immunity, may play an important role in host protection upon virus infection PMID: 29280086
- Using MAVS as a platform, NLRP11 degrades TRAF6 to attenuate the production of type I IFNs as well as virus-induced apoptosis. Our findings reveal the regulatory role of NLRP11 in antiviral immunity by disrupting MAVS signalosome. PMID: 29097393
- Low MAVS expression is associated with RNA virus infections. PMID: 29743353
- The down regulation of TRIF, TLR3, and mitochondrial antiviral signaling protein (MAVS) expressions in chronic hepatitis C correlates with the disease severity and the outcome of hepatitis C virus infection PMID: 28480979
- Taken together, these findings reveal an essential role of CypA in boosting RIG-I-mediated antiviral immune responses by controlling the ubiquitination of RIG-I and MAVS. PMID: 28594325
- Data show that human cytomegalovirus (HCMV; human betaherpesvirus 5) glycoprotein US9 inhibits the IFN-beta response by targeting the mitochondrial antiviral-signaling protein (MAVS) and stimulator of interferon genes (STING)-mediated signaling pathways. PMID: 29317664
- our results demonstrate that miR-22 negatively regulates poly(I:C)-induced production of type I interferon and inflammatory cytokines via targeting MAVS. PMID: 27705941
- this analysis did not indicate the association of the MAVS locus with susceptibility to Addison's disease and type 1 diabetes PMID: 27652379
- In the late phase of RNA viral infection, iRhom2 mediates proteasome-dependent degradation of the E3 ubiquitin ligase MARCH5 and impairs mitochondria-associated degradation (MAD) of VISA. PMID: 29155878
- findings suggest that oxidative stress-induced MAVS oligomerization in SLE patients may contribute to the type I IFN signature that is characteristic of this syndrome. PMID: 27899525
- findings reveal a negative feedback loop of RLR signaling generated by Tetherin-MARCH8-MAVS-NDP52 axis and provide insights into a better understanding of the crosstalk between selective autophagy and optimal deactivation of type I IFN signaling. PMID: 28965816
- Studied association of genetic variants of the MAVS, MITA and MFN2 genes with leprosy in Han Chinese from Southwest China; found no association between the variants and susceptibility to leprosy. PMID: 27553710
- Mechanistic studies showed that HACE1 exerts its inhibitory role on virus-induced signaling by disrupting the MAVS-TRAF3 complex. PMID: 27213432
- this study shows that keratinocytes are an important source of IFN-beta and MAVS is critical to this function, and demonstrates how the epidermis triggers unwanted skin inflammation under disease conditions PMID: 27438769
- Herpes simplex virus 1 blocks MAVS-Pex mediated early interferon-stimulated gene activation through VP16 to dampen the immediate early antiviral innate immunity signaling from peroxisomes. PMID: 28222744
- This study demonstrates a novel pathway for elevated IFNbeta signaling in SLE that is not dependent on stimulation by immune complexes but rather is cell intrinsic and critically mediated by IFNbeta and MAVS. PMID: 28471483
- TTLL12 as a negative regulator of RNA-virus-induced type I IFN expression by inhibiting the interaction of VISA with other proteins. PMID: 28011935
- Therefore, Seneca Valley virus suppressed antiviral interferon production to escape host antiviral innate immune responses by cleaving host adaptor molecules MAVS, TRIF, and TANK by its 3C protease. PMID: 28566380
- GPATCH3 interacts with VISA and disrupts the assembly of virus-induced VISA signalosome therefore acts as a negative regulator of RLR-mediated innate antiviral immune responses. PMID: 28414768
- this study shows that MAVS silencing upregulates IFN-beta production via upregulation of NF-kappaB and IRF3 signaling PMID: 27593154
- DDX3 directly regulates TRAF3 ubiquitination and acts as a scaffold to co-ordinate assembly of signaling complexes downstream from MAVS. PMID: 27980081
- this study identified three single nucleotide polymorphisms within MAVS that showed significant differences in plasma HIV-1 viral load PMID: 28024153
- Results indicate that TAX1BP1 functions as an adaptor molecule for Itch to target MAVS during RNA virus infection and thus restrict virus-induced apoptosis. PMID: 27736772
- Deficiency of MAVS in hematopoietic cells resulted in increased mortality and delayed West Nile Virus clearance from the brain. PMID: 27226371
- Can activate the RLR/MAVS pathway. PMID: 27605671
- deliberately targeting the evolutionarily conserved MDA-5-IPS-1 antiviral pathway in tumors can provoke parallel tumoricidal and immunostimulatory effects that bridge innate and adaptive immune responses for the therapeutic treatment of cancer PMID: 26893477
- Pyruvate carboxylase activates the RIG-I-like receptor-mediated antiviral immune response by targeting the MAVS signalosome. PMID: 26906558
- This study identified new functional alterations in antiviral signalling based on MAVS polymorphisms PMID: 26954674
- Data show that the NS3 protein of dengue virus bound to 14-3-3 epsilon protein (14-3-3varepsilon) and prevented translocation of retinoic acid-inducible gene-I protein (RIG-I) to the adaptor MAVS protein and thereby blocked antiviral signaling. PMID: 26998762
- These results demonstrate that poliovirus infection actively suppresses the host type I interferon response by blocking activation of IRF-3 and suggests that this is not mediated by cleavage of MDA-5 or IPS-1. PMID: 26437794
- Results show MAVS-transmembrane domain is shown to oligomerize in response to changes in the outer mitochondrial lipid membrane properties caused by treatment with mitochondrial reactive oxygen species inducers or by Sendai virus infection. PMID: 26317833
- These results suggest that vIRF-1 is the first example of a viral protein to inhibit mitochondrial antiviral signaling through lipid raft-like microdomains. PMID: 26512076
- An autoinhibitory mechanism modulates MAVS activity in unstimulated cells and, on viral infection, individual regions of MAVS are released following MAVS filament formation to activate antiviral signalling cascades. PMID: 26183716
- indicate comparable activation of the IFN response by pex- and mito-mitochondrial antiviral-signaling protein in hepatocytes and efficient counteraction of both MAVS species by the HCV nonstructural protein 3 protease PMID: 26588843
- MAVS50, exposing a degenerate TRAF-binding motif within its N-terminus, effectively competed with full-length MAVS for recruiting TRAF2 and TRAF6 PMID: 26221961
- IPS-1 induces anticancer activity through upregulation of pro-apoptotic gene TRAIL and downregulation of the anti-apoptotic genes BCL2, BIRC3 and PRKCE via IRF3 and IRF7 in type I interferon-dependent and -independent manners. PMID: 25950488
- Transmembrane motif T6BM2-mediated TRAF6 binding is required for MAVS-related antiviral response. PMID: 26385923
- During Crimean-Congo hemorrhagic fever virus infection, RIG-I mediated a type I interferon response via MAVS. PMID: 26223644
- Polymorphisms in IPS1 are independently associated with treatment response to PEG-IFN among Chinese HBeAg-positive CHB patients. PMID: 25640825
- Elucidate the structural mechanism of MAVS polymerization, and explain how an alpha-helical domain uses distinct chemical interactions to form self-perpetuating filaments. PMID: 24569476
- pVHL Negatively Regulates Antiviral Signaling by Targeting MAVS for Proteasomal Degradation PMID: 26179906
- Notably, in Lymphocytic Choriomeningitis Virus-infected cells, RIG-I was dispensable for virus-induced apoptosis via MAVS. PMID: 25833049
- Hepatitis C virus NS3-4A similarly diminished both human and mouse MAVS-dependent signaling in human and mouse cells and MAVS induces both type I and type III interferons, which together control the hepatitis C virus replication. PMID: 25609814
- plays an essential role in stress granule formation PMID: 24659800
- findings show MAVS and STING harbor 2 conserved serine and threonine clusters that are phosphorylated by IKK and/or TBK1 in response to stimulation; results reveal phosphorylation of innate adaptor proteins is an essential and conserved mechanism that selectively recruits IRF3 to activate the type I IFN pathway PMID: 25636800
- MAVS did not reveal significant single-SNP associations with multiple sclerosis risk. PMID: 25288302
- Data indicate that DEAH-box RNA helicase DHX15/PRP43 stimulates the NF-kappaB and MAPK pathways downstream of virus-induced signaling adapter protein MAVS and contributes to MAVS-mediated cytokine production and apoptosis. PMID: 24782566
顯示更多
收起更多
-
亞細胞定位:Mitochondrion outer membrane. Mitochondrion. Peroxisome.
-
組織特異性:Present in T-cells, monocytes, epithelial cells and hepatocytes (at protein level). Ubiquitously expressed, with highest levels in heart, skeletal muscle, liver, placenta and peripheral blood leukocytes.
-
數據庫鏈接:
Most popular with customers
-
-
YWHAB Recombinant Monoclonal Antibody
Applications: ELISA, WB, IHC, IF, FC
Species Reactivity: Human, Mouse, Rat
-
Phospho-YAP1 (S127) Recombinant Monoclonal Antibody
Applications: ELISA, WB, IHC
Species Reactivity: Human
-
-
-
-
-